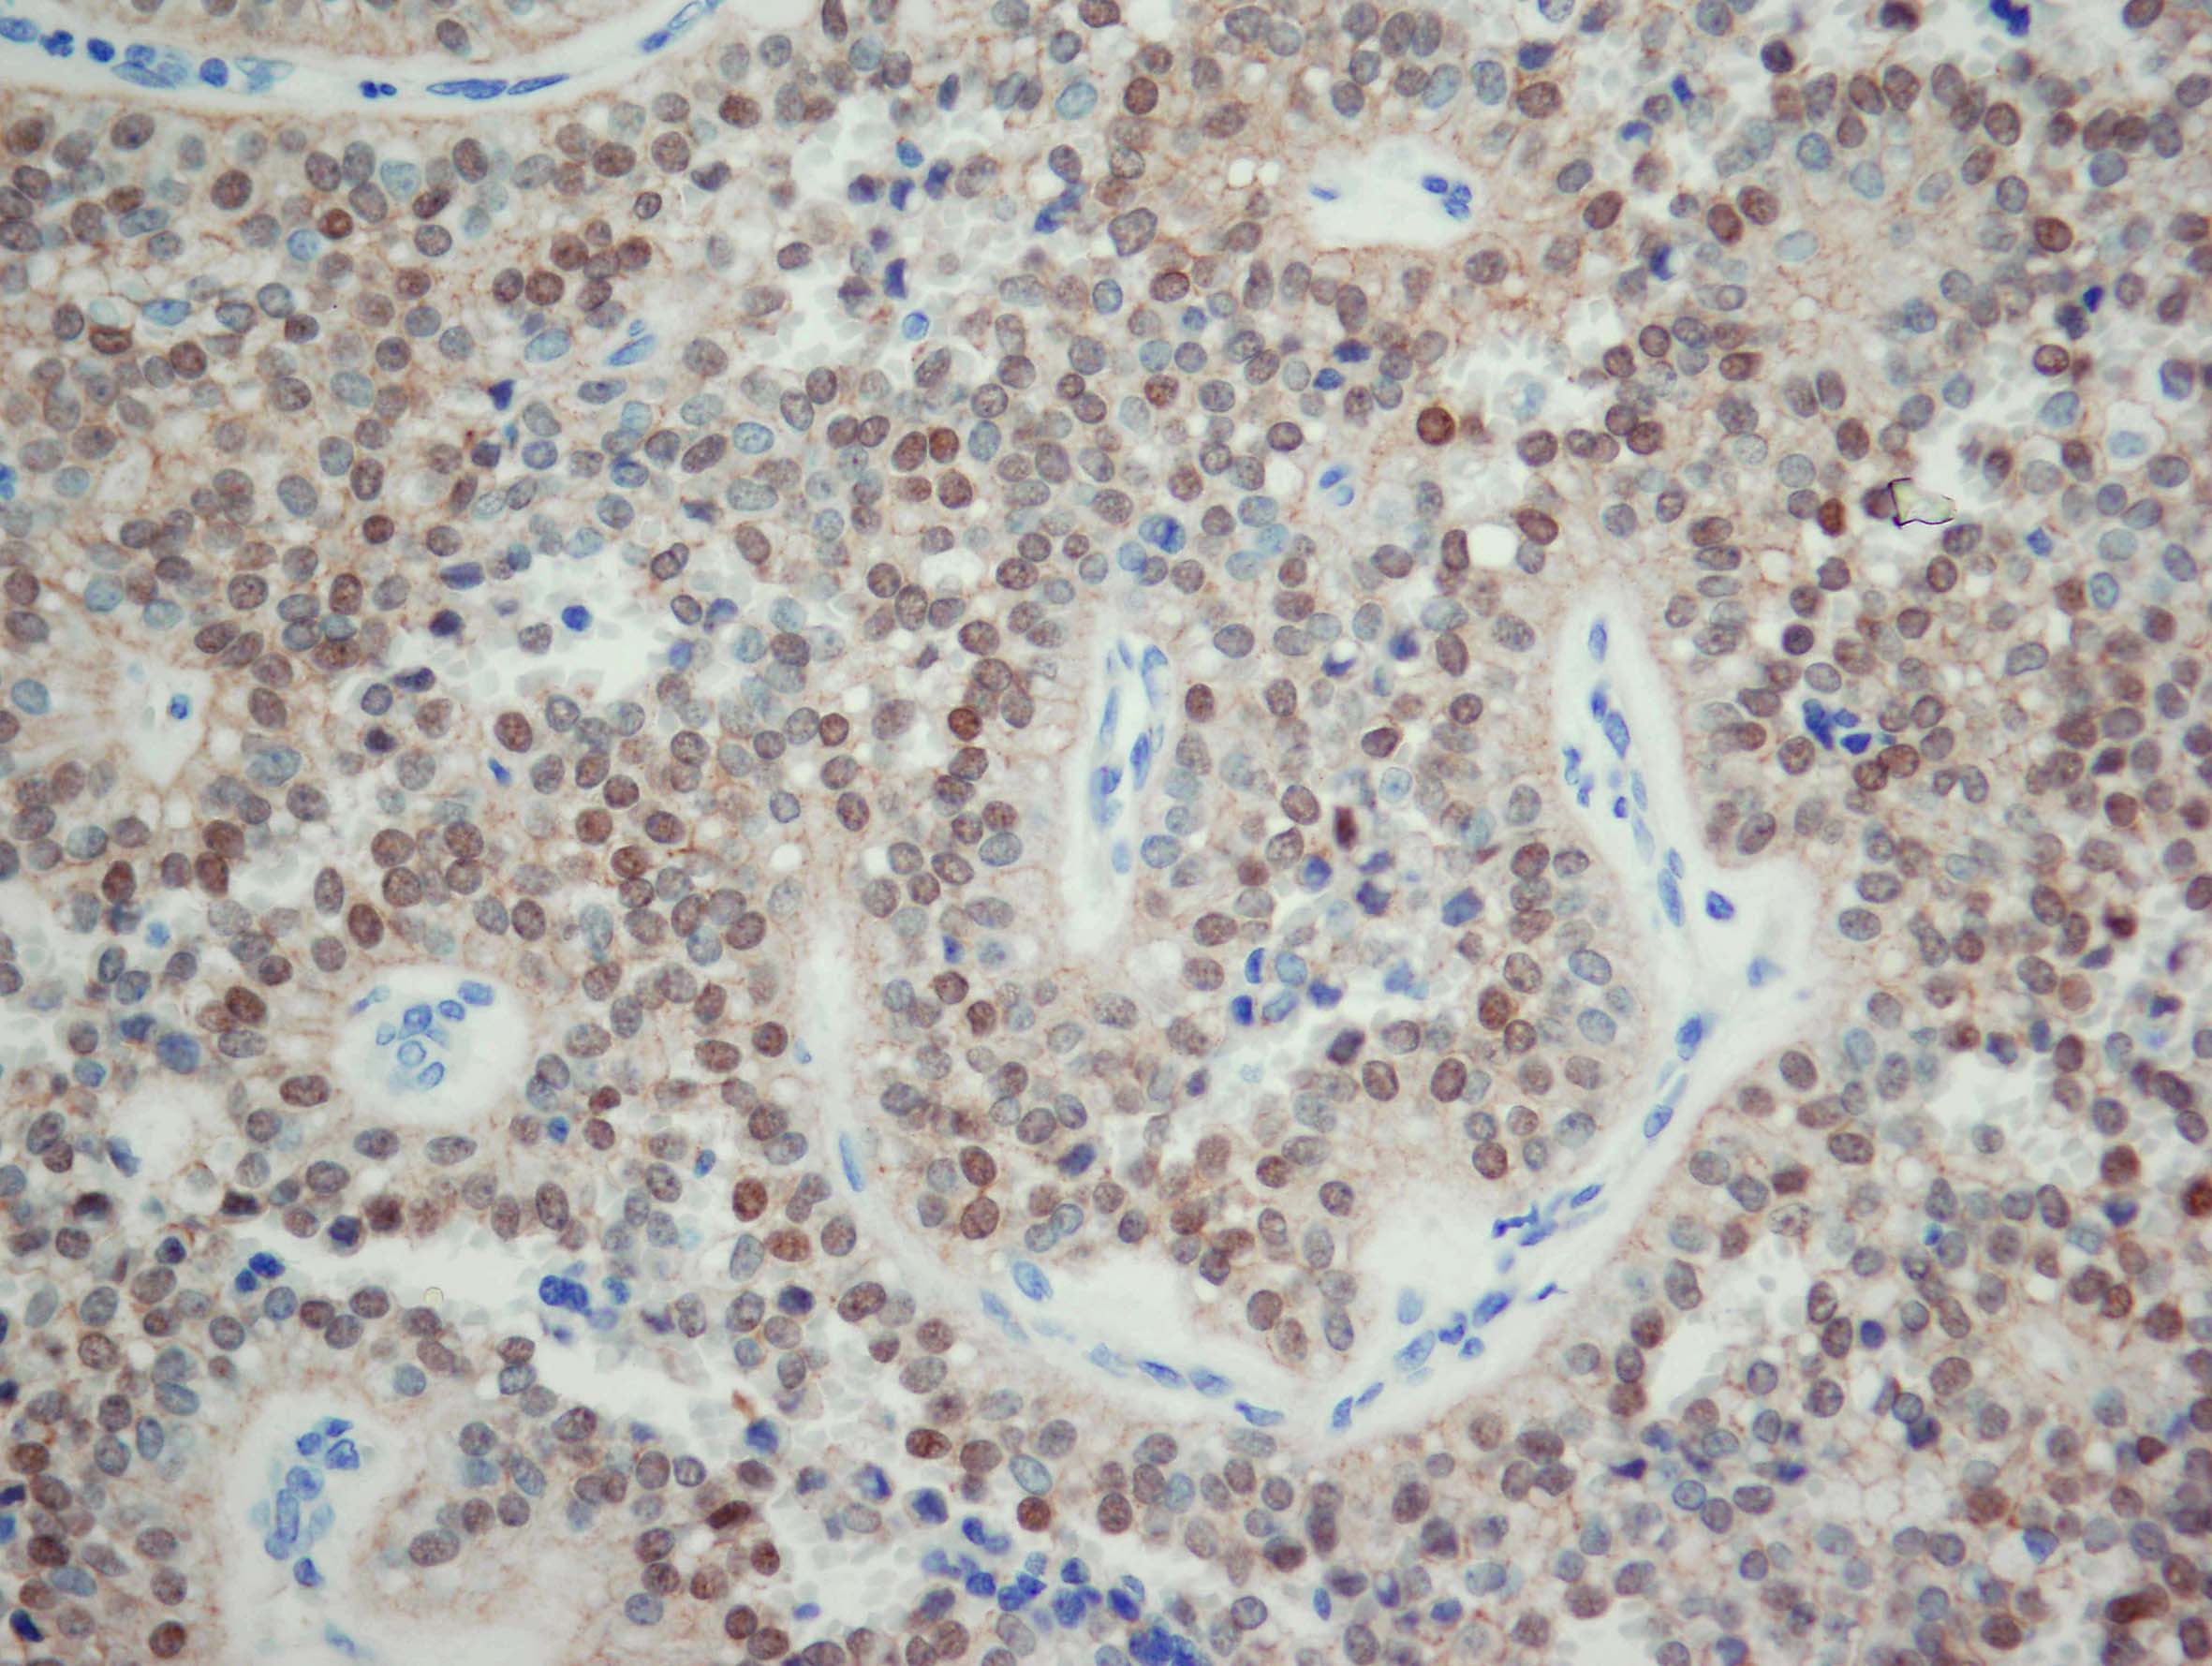

KURS ZA SPECIJALIZANTE PATOLOGIJE U OKVIRU TRENINGA IZ PATOLOGIJE GASTROINTESTINALNOG TRAKTA I PANKREASA

Integrisane akademske studije - Patologija
Onlajn kursevi Katedre za patologiju
KURS ZA SPECIJALIZANTE PATOLOGIJE U OKVIRU TRENINGA IZ PATOLOGIJE GASTROINTESTINALNOG TRAKTA I PANKREASA

Integrisane akademske studije - Patologija